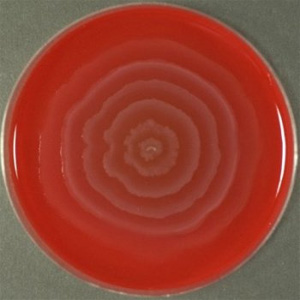
Согласованные массовые передвижения (swarming) бактерий Proteus mirabilis приводят к образованию характерных концентрических колец на поверхности питательной среды. Фото с сайта www.microbiologyatlas.kvl.dk

Американские микробиологи выявили в геноме бактерии Proteus mirabilis участок, отвечающий за самоидентификацию и взаимное узнавание микробов. Мутации в этом участке могут приводить к мгновенному разделению популяции микробов на группы, относящиеся друг к другу как к «чужакам». Представители таких групп отказываются образовывать смешанные скопления, что можно рассматривать как начальный этап видообразования.
Способность отличать своих от чужих — одно из фундаментальных свойств живых организмов. На этой способности основаны важнейшие биологические процессы и явления, в том числе половое размножение (выбор партнера), видообразование (формирование репродуктивной изоляции), защита от патогенных микробов и вирусов, отторжение чужеродных тканей, колониальность, многоклеточность, социальность, включая разные формы кооперации и даже альтруизма (который, как правило, направлен на «своих», прежде всего на родственников).
В ходе эволюции у разных организмов развились разнообразные, в том числе весьма сложные и эффективные, механизмы различения своего и чужого. У высших организмов (эукариот) эти механизмы изучены значительно лучше, чем у прокариот (бактерий и архей). Однако у прокариот они тоже имеются. Например, многие бактерии ведут общественный образ жизни и даже способны к своеобразным проявлениям альтруизма (см.: Бактерии-альтруисты помогают своим сородичам-каннибалам себя съесть, «Элементы», 27.02.2006). Если бы микробы совершенно не умели отличать своих от чужих (то есть родственников от неродственников), естественный отбор не смог бы развить у них сложное социальное поведение и тем более альтруизм (см.: Родственный отбор).
Генетические и биохимические основы различения своих и чужих у бактерий изучены пока слабо, и каждое новое открытие в этой области привлекает к себе большое внимание. Американские микробиологи сообщили в последнем номере журнала Science о расшифровке механизма взаимной идентификации у бактерии протея (Proteus mirabilis). Этот микроб живет в пищеварительном тракте человека и обычно безвреден, но при неблагоприятном стечении обстоятельств может вызывать инфекции мочевыводящей системы. Для протея характерно сложное социальное поведение, выражающееся, в частности, в согласованных передвижениях больших групп бактериальных клеток (см. Swarming motility).
У протея есть свойство, делающее его очень удобным объектом для изучения механизмов различения своих и чужих. Когда две колонии или «стаи» (swarms) Proteus mirabilis встречаются на поверхности питательной среды, происходит одно из двух: либо колонии сливаются, либо они сохраняют самостоятельность. В последнем случае между ними образуется хорошо видимая граница. Выбор одного из двух вариантов зависит от степени родства. Если обе стаи принадлежат к одному и тому же штамму (клону, генетической линии), они, скорее всего, сольются; если к разным — между ними, скорее всего, возникнет граница. Данная особенность используется в медицинской практике для идентификации штаммов микроба.
Ранее было установлено, что многие штаммы Proteus mirabilis выделяют токсичные белки — протицины, предназначенные для борьбы с конкурирующими штаммами. Каждый штамм выделяет свой протицин, к которому он устойчив, и к тому же обладает устойчивостью к некоторым (но не всем) чужим протицинам. Однако образование границ между неродственными стаями определяется не протицинами, а чем-то другим. Дело в том, что некоторые штаммы не выделяют протицинов, но при этом всё равно образуют границы, в том числе и с другими штаммами, лишенными протицинов.
Чтобы выяснить причины этого явления, исследователи заставили бактерий быстро мутировать, активизировав перемещения мобильных генетических элементов (транспозонов). Из одного «предкового» штамма (BB2000) было получено 3600 мутантных штаммов-потомков. Среди них обнаружился один, который отказался смешиваться с другими мутантами и с предковым штаммом BB2000. Его назвали Ids (от слов «identification of self» — «самоидентификация»). Очевидно, в штамме Ids произошла мутация, заставившая этот штамм изменить свою самоидентификацию и начать воспринимать родительский штамм BB2000 как «чужой».

Теперь нужно было выяснить природу этой мутации. Оказалось, что у штамма Ids транспозон встроился в участок генома, содержащий шесть генов, функции которых до сих пор не были известны. Ученые обозначили этот участок idsABCDEF. По-видимому, транспозон нарушил нормальную работу этих генов, что и привело к «отчуждению» бактерий-мутантов от предков и родственников.
Чтобы проверить это предположение, у бактерий из предкового штамма BB2000 удалили все шесть генов. Получились мутанты, которые считали штамм Ids «своим», а предков — «чужими». Стало ясно, что данные шесть генов действительно играют ключевую роль в самоидентификации бактерий и в различении своих и чужих.
После этого началась кропотливая генно-инженерная работа с целью выяснения функций каждого из шести генов в отдельности. Эта работа еще далека от завершения: ученые пока сообщили только о предварительных результатах.
Выяснилось, что удаление гена idsA само по себе не ведет к изменению самоидентификации бактерий. Этот ген, по-видимому, играет какую-то вспомогательную роль. Однако удаление или поломка хотя бы одного из генов idsB, idsC, idsD, idsE, idsF приводит к тому, что бактерии начинают считать предковый штамм «чужим». При этом бактерии, у которых удален ген B, C, D или E, считают «своими» бактерий, у которых удалены все шесть генов. Однако бактерии с удаленным геном F считают «чужими» всех, кроме самих себя.
Исследователи обнаружили, что похожие генетические системы идентификации есть и у других штаммов Proteus mirabilis, а также у других видов бактерий. Была проведена дополнительная серия экспериментов, в которой участок idsABCDEF пересаживался (целиком или по частям) другому, неродственному штамму Proteus mirabilis (штамм HI4320) вдобавок к его собственной генетической идентификационной системе. Бактерии из штамма HI4320, которым участок idsABCDEF от штамма BB2000 пересадили целиком, начинают считать свой родной штамм HI4320 «чужим». Однако если в пересаженном участке поврежден ген D или E, отчуждения не происходит: бактерии продолжают считать штамм HI4320 «своим».
Эти и другие, еще более сложные эксперименты позволили ученым установить, что самую важную роль в различении своих и чужих играют гены D и E. Именно они определяют «индивидуальность» бактерии. В этих генах обнаружились вариабельные области, то есть участки, сильно различающиеся у разных штаммов. Гены D и E образуют уникальную генетическую «идентификационную карточку», по которой штаммы бактерий различают друг друга.
Гены B, C и F, по-видимому, нужны для того, чтобы эта «идентификационная карточка» могла быть должным образом представлена и опознана. У разных штаммов эти гены различаются слабо (имеют похожие нуклеотидные последовательности), и если взять любой из этих генов у одного штамма и пересадить другому, самоидентификация бактерий не изменится.
Судя по ряду косвенных признаков, система идентификации у Proteus mirabilis не ограничена участком idsABCDEF. Скорее всего, существуют и другие, пока еще не выявленные гены, участвующие в различении своих и чужих. Вся система в целом может оказаться весьма сложной и многоплановой.
Исследование наглядно продемонстрировало, что одной-единственной мутации может быть достаточно для радикального изменения самоидентификации организмов: мутанты начинают считать родительский штамм «чужим» и отказываются образовывать с ним смешанные колонии. Конечно, это нельзя назвать видообразованием в полном смысле слова — понятие «видообразование» вообще довольно трудно приложить к организмам, лишенным настоящего полового размножения. Но возможные аналогии и параллели вполне очевидны. По крайней мере, ясно, что у организмов с половым размножением от «несмешиваемости» популяций, отказа от образования смешанных групп, до «нескрещиваемости» — главного критерия видообразования — самое большее один шаг.
Источник: Karine A. Gibbs, Mark L. Urbanowski, E. Peter Greenberg. Genetic Determinants of Self Identity and Social Recognition in Bacteria // Science. 2008. V. 321. P. 256–259.
См. также:
1) Как отличить своих от чужих? Неканонические механизмы репродуктивной изоляции.
2) Видообразование — личное дело каждого, «Элементы», 15.02.2006.
3) А. В. Марков, А. М. Куликов. Гипотеза иммунологического тестирования партнеров — системы распознавания «своих» и «чужих» в исторической перспективе.



